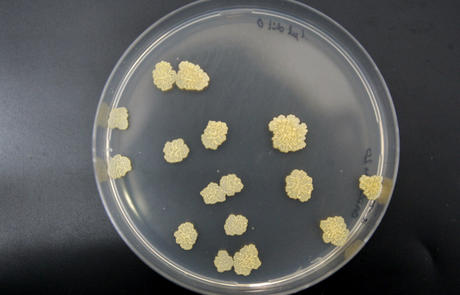

“Acabar con la tuberculosis salvará más de tres millones de vidas en Europa”
Imagen de archivo de un cultivo de Mycobacterium tuberculosis, la bacteria que causa esta enfermedad infecciosa
En la última década los casos de tuberculosis en Europa se están reduciendo un 4,3 por ciento cada año, si bien este porcentaje es “insuficiente” para acabar con la epidemia en 2030, según un nuevo informe del Centro Europeo para la Prevención de Enfermedades y Control (ECDC) y la Oficina Regional de la Organización Mundial de la Salud (OMS) para Europa.
“No es suficiente para acabar con la enfermedad. Necesitamos dar un paso adelante para obtener beneficios a nivel individual y social. El Plan de Acción contra la Tuberculosis para la Región Europea de la OMS 2016-2020 muestra que las acciones audaces salvarán más de tres millones de vida en Europa”, ha comentado la directora general de la OMS para Europa, Zsuzsanna Jakab.
Por ello, ha abogado por renovar el compromiso político a todos los niveles con el fin de lograr resultados “tangibles e inmediatos” que cambien y salven las vidas de todas las personas que sufren de tuberculosis y, de esta forma, garantizar un mundo libre de enfermedad para las generaciones futuras.
“La Comisión Europea está plenamente comprometida para ayudar a los estados miembros a alcanzar el objetivo de acabar con la tuberculosis para 2030. Exhorto a los líderes en Europa a adoptar un enfoque multisectorial de la tuberculosis, movilizando los fondos necesarios para la investigación, garantizando el acceso a la atención médica preventiva y curativa para todos, y abordar las condiciones sociales que fomentan su propagación”, ha dicho el comisario europeo de Sanidad y Seguridad Alimentaria, Vytenis Andriukaitis.
Asimismo, la directora de la ECDC, Andrea Ammon, ha añadido la importancia de que permanecer atentos a la tuberculosis, incluso en casos de baja incidencia, debido al posible resurgimiento de esta enfermedad en el aire, especialmente por el incremento de la movilidad de la población y de la tuberculosis multirresistente.
Un “importante” problema de salud pública
A pesar de los progreso, la tuberculosis, especialmente en sus formas resistentes a los medicamentos, sigue siendo un “importante” problema de salud pública. De hecho, los últimos datos del informe de vigilancia y monitoreo de la patología indican que uno de cada cuatro casos de tuberculosis resistente no se detecta en la Región Europea de la OMS.
En este sentido, los expertos han informado de que el aumento observado en el éxito del tratamiento, del 46 por ciento en 2013 al 55 por ciento en 2016, sigue siendo “insuficiente” para que los países europeos logren la meta del 75 por ciento en 2020 con la que se comprometieron en el plan de acción.
Finalmente, y para hacer frente a la amenaza de la tuberculosis resistente a los medicamentos, el ECDC lanzó un proyecto piloto en 2017 sobre el uso de la secuenciación completa del genoma (WGS) para mejorar la detección e investigación.












Impedir la entrada de inmigrantes ilegales a su vez evitaría el 95% de la tuberculosis de España.